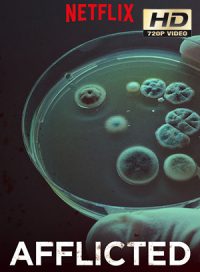
pelicula Enfermedades Del Siglo XXI

Enfermedades Del Siglo XXI
Género:
Fecha:
12-08-2018
Pais:
Estados Unidos
Resumen:
Sintomas desconcertantes. Diagnosticos controvertidos. Tratamientos caros. Siete personas que sufren enfermedades cronicas buscan respuestas y consuelo.
Películas Relacionadas
| Nombre | Fecha |
|---|---|
| Pelicula The Occupant | 14-04-2026 |
| Pelicula El último rodeo | 14-04-2026 |
| Pelicula Siempre es invierno | 14-04-2026 |
| Pelicula Reversión | 14-04-2026 |
| Pelicula Pretty Lethal | 14-04-2026 |


